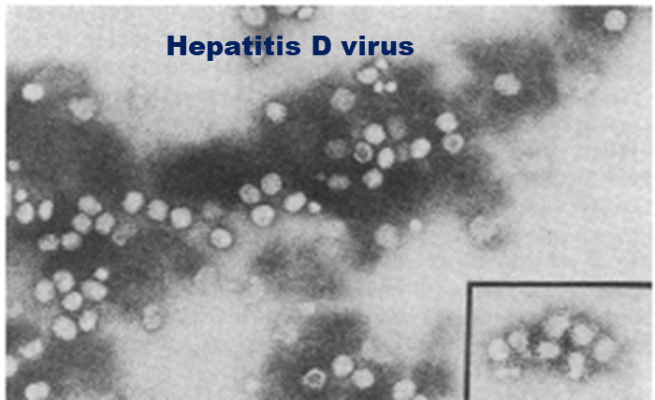
Xét nghiệm viêm gan virus D - Ảnh BSCC

Hepatitis D virus (HDV) lần đầu tiên được báo cáo năm 1977 khi nghiên cứu trên nhóm bệnh nhân viêm gan B mạn tính nặng, là vi rút không hoàn thiện do cần HBsAg của vi rút viêm gan B (HBV) để xâm nhập vào tế bào gan và thoát ra khỏi tế bào để hoàn thành vòng đời của mình.
Do vậy nhiễm HDV chỉ xảy ra 1 trong 2 trường hợp là đồng nhiễm với HBV hoặc bội nhiễm trên bệnh nhân viêm gan B mạn tính. Ước tính có ít nhất 12 triệu người nhiễm HDV toàn cầu (tương ứng với khoảng 5% bệnh nhân nhiễm HBV).
![]() |
| Xét nghiệm viêm gan virus D - Ảnh BSCC |
Đồng nhiễm HBV/HDV gây bệnh cảnh lâm sàng nguy hiểm hơn và làm tăng tỷ lệ tử vong so với đơn nhiễm HBV, tuy nhiên đồng nhiễm 2 virus này ở người lớn dẫn đến sự thải trừ virus ở đa số các cá nhân tương tự như nhiễm HBV cấp. Trong khi đó bội nhiễm HDV ở bệnh nhân nhiễm HBV mạn tính trên 90% trường hợp dẫn đến nhiễm HDV mạn tính và tiến triển nhanh đến xơ gan và ung thư gan.
Theo GS Rizzeto, người phát hiện HDV năm 1977, khoảng 50-70% bệnh nhân đồng nhiễm HBV/HDV mạn tính sẽ dẫn đến xơ gan trong khoảng 5-10 năm, gấp 3 so với đơn nhiễm HBV và khoảng 25% bệnh nhân HBV được ghép gan ở châu Âu là đồng nhiễm HBV/HDV.
Bộ Y tế nước ta trong quyết định số 3310/QĐ-BYT năm 2019 khuyến cáo các bệnh nhân nhiễm HBV có tải lượng HBV DNA thấp và nồng độ ALT cao; và nhóm đối tượng nguy cơ cao (nhiễm HIV, tiêm chích ma túy, quan hệ đồng tính nam, mắc bệnh lây truyền qua đường tình dục) cần xét nghiệm anti-HDV.
![]() |
| Đồng nhiễm viêm gan virus B và D tăng nguy cơ tử vong - Ảnh minh họa |
Theo hiệp hội gan mật châu Âu, bệnh nhân có HBsAg dương tính được khuyến cáo xét nghiệm sàng lọc nhiễm HDV bằng kỹ thuật phát hiện kháng thể kháng HDV (anti-HDV) ít nhất 1 lần trong đời và các bệnh nhân dương tính với anti-HDV cần được xét nghiệm HDV RNA, HBV DNA theo định kỳ.
Xét nghiệm phát hiện anti-HDV hỗ trợ cho chẩn đoán nhiễm HDV trên bệnh nhân nhiễm HBV được Khoa Vi sinh vật, Bệnh viện TWQĐ 108 triển khai từ tháng 5/2024.
TS.BS Bùi Tiến Sỹ (Khoa Vi sinh vật, Trung tâm xét nghiệm, Bệnh viện TWQĐ 108)